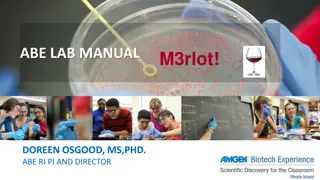

Lab # 4
Inflammation is the body's response to injury, characterized by redness, heat, swelling, and pain. Explore the causes, types, and components of inflammation along with images depicting the process. Understand the vascular phase and inflammatory mediators involved in the response. Learn about how tissues are damaged and the cardinal signs of acute inflammation. Witness the body's intricate defense mechanisms in action.
Download Presentation

Please find below an Image/Link to download the presentation.
The content on the website is provided AS IS for your information and personal use only. It may not be sold, licensed, or shared on other websites without obtaining consent from the author.If you encounter any issues during the download, it is possible that the publisher has removed the file from their server.
You are allowed to download the files provided on this website for personal or commercial use, subject to the condition that they are used lawfully. All files are the property of their respective owners.
The content on the website is provided AS IS for your information and personal use only. It may not be sold, licensed, or shared on other websites without obtaining consent from the author.
E N D
Presentation Transcript
Lab Animals will be used in PHL 322 Mouse Animal expression 058 Don t worry you will see it again in EXAM Mouse http://www.criver.com/SiteCollectionImages/Images_255x164/rms_rat_white1_0013_lres.jpg Today http://t3.gstatic.com/images?q=tbn:ANd9GcSTFyO4AihrOYarcGoZqzNTJO76LPP_JhC4hIjjcpCn397wtblr Rat Lastlab. Frog
Etiology 1- pathogenic organism 2- trauma a. Mechanical b. Thermal c. Chemical / toxic etc 3- ischemia 4- immunologic It is a reaction of living tissue to an injury. Causes Types L. Inflammo Acute Rapid onset , Short duration Chronic Gradual onset , long duration set on fire Cardinal signs of acute inflammation: 1.Redness 2.Hotness 3.Swelling 4.Pain and tenderness Medical terms Itis- This suffix has come to mean "inflammation of - Hepatitis= inflammation of liver - Meningitis= inflammation of mening
Component of Inflammation 1. Vascular Increased vasodilatation leads to increased permeability of the vascular to plasma protein. 2. Cellular Involves migration of tissue macrophages and polymorphonuclear leukocytes (PMNL) to the inflamed area. Inflammatory Mediators Mediator Main activity Histamine Vasodilation, increase permeability Prostaglandins ( PGs ) Vasodilation, pain, fever Leukotrienes (LKs) Increase permeability Bradykinin Vasodilation, increase permeability, pain Serotonin Cytokines (IL-1, TNF) Complement Nitric oxide
Inflammatory process (( vascular phase)) Tissues damage Release inflammatory mediators a.Histamine b.PGE2 c.LKs d.Bradykinin Vasodilation (V.D.) Increase blood flow Cardinal signs of acute inflammation: 1.Redness: due to V.D 2.Hotness: due to V.D. and increase blood flow 3.Swelling: due to vascular leakage 4.Pain and tenderness: due to irritation by chemical mediators and pressure of swelling Increase vascular permeability lead to formation of fluid exudate((plasma protein)) Edema Formation Very important symptom to measurement effect of anti-inflammatory
http://faculty.riohondo.edu/rbethel/videos/micro_inflammation.swf
Inflammatory process Dilation of the blood vessels increase the blood flow to the area, accounting for redness and heat observed. Increased permeability of the capillaries allows plasma to leak from the blood stream into the tissue spaces, causing local edema (swelling) that also activates pain receptors in the area. Aiming of the inflammation response (1) prevents the spread of damaging agents to nearby tissues, (2) disposes of cell debris and pathogens, and (3) sets the stage for repair.
Anti-inflammatory NSAIDS Antihistamines Corticosteroids Immunosuppressant Newer biologic agents Drugs for gout
Steroidal Non-steroidal Glucocorticoids NSAIDs like - Aspirin - aspirin don t contain steroid moiety Containing steroid moiety
Under CNS control Trigger to Secreted CRH from hypothalamus Secreted ACTH from anterior pituitary gland Stimulation to Stimulation to Adrenal gland cortisol : is predominant glucocorticoids in human glucocorticoids : are steroids hormones which include cortisone and cortisol (hydrocortisone) Secreted glucocorticoids from adrenal cortex
GLUCOCORTICOIDS Clinical uses A- adrenal disorders: like Addison's disease B- Nonadrenal disorders : a. Anti-inflammatory for treatment asthma as example b. Immunosuppression: to prevent organ transplant rejection c. ..etc. Synthetics Prednisone Dexamethasone Beclomethasone Flunisolide Fluticasone Natural - Cortisol - Cortisone One of the MOA They act by indirect inhibition of the enzyme phospholipase A2 by induce synthesis of a protein lipocortin-1 which has the inhibitory effect on phospholipase A2. Some Adverse Effects - Hyperglycemia - Osteoporosis - Moon face, buffalo hump
Non- Steroidal Anti-Inflammatory Drugs Cox-2 selective inhibitor (coxib) Cox non-selective inhibitors Example : - Aspirin, - Ibuprofen, - Diclofenac etc Example - Celecoxib ((has a FDA initiated black box warning concerning cardiovascular risk)) MOA Inhibit synthesis of PGs through inhibition of COX
glucocorticoids NSAID Containing steroid moiety in their structure They don t contain steroid moiety Powerful anti-inflammatory , immunosuppression, adrenal disorder anti-inflammatory, analgesic, antipyretic anti-platelet ((only aspirin)) Prevent synthesis of LKs and PGs Prevent synthesis of PGs Treatment of asthma Can be caused asthma
Measurement the activity of anti-inflammatory drugs Method : Paw Oedema Method Equipment : Plethysmometer Any instrument designed to measure small changes in volume, usually via the displacement of water Principle : Induction a chemical inflammation by injecting an irritant ( formalin ) into rat s paw Objective : Measure the anti-inflammatory activity of aspirin and hydrocortisone (cortisol) with different doses
-Procedure : 1- select 5 rats 2- inject each rat 1 ml urethane for anesthesia. 3- select one as control and inject the rest of them Intraperitoneal (IP) rat 1 >>> control rat 2 >>> 40 mg/kg aspirin rat 3 >>> 80 mg/kg aspirin rat 4 >>> 20 mg/kg hydrocortisone rat 5 >>> 40 mg/kg hydrocortisone 4- after 1 hr. , inject 0.1 ml formalin in each rat into their paws >>> to induce inflammation. 5- after 1 hr. , take the reading using the plethysmometer of each rat paw ( right and left ). 6- calculate the inflammation and response % for each drug.
Control aspirin Hydrocortisone Each Rat 1 ml Urethane control (IP) 40 mg/kg 80 mg/kg 20 mg/kg 40 mg/kg No drug After 1 hr. Each rat 0.1 ml Formalin in one paw After 1 hr. Take the reading using the plethysmometer for right paw (RP) and left paw (LP)
Dose LP RP inflammation Response% control C ---------- 40 mg/kg asp. T1 80 mg/kg asp. T2 20 mg/kg hydro. 40 mg/kg hydro. T3 T4 Inflammation = LP - RP Response % =? ? ??? ?
Dose LP RP 1.02 1.2 1.25 inflammation Response% --------- 37.74 69.81 1.55 1.53 1.41 control 40 mg/kg asp. 0.53 0.33 40 mg/kg hydro. 0.16 Inflammation for - Control ((C)) : 1.55-1.02 = 0.53 - Asprirn : 1.53- 1.2 = 0.33 - Hydrocortisone : 1.41-1.25 = 0.16 Inflammation = LP - RP Response % of aspirin =0.53 0.33 100 = 37.74% 0.53 Response % =? ? ??? ? Response % of hydro. =0.53 0.16 100 = 69.81% 0.53 Response % Anti-inflammatory activity